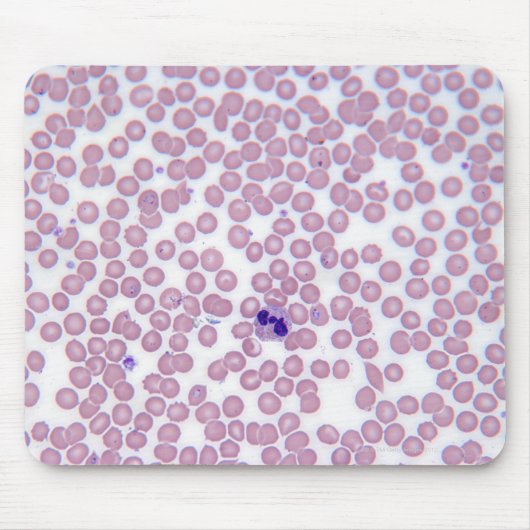
Malariablutzellen Mousepad (Vorne)

Über Mousepads
Verkauft von
Über dieses Design
Malariablutzellen Mousepad
Malariische Blutzellen | "Michael J. Klein, M.D." | AssetID: 142021985
Automatische Übersetzung
Kundenrezensionen
4.6 von 5 Sternen Bewertung47 Bewertungen insgesamt
47 Bewertungen
Bewertungen für ähnliche Produkte
5.0 von 5 Sternen Bewertung
5 von 5 Sternen BewertungVon C.19. Februar 2023 • Geprüfter Kauf
Mousepad
Bewertungsprogramm bei Zazzle
An sich wollte ich ein Mousepad dass farbtechnisch mit der Akzentfarbe meines Arbeitszimmers übereinstimmt. Und da man über Bitmoji dem noch einen schönen personalisierten Touch verabreichen kann, war das eine gute Wahl. Produkt ist sehr schön, wirkt gut verarbeitet und funktioniert auch fein. Der Druck war sehr gut. Im Prinzip sieht es ziemlich genau aus wie auf der Voransicht. Bin in der Hinsicht sehr zufrieden.
5.0 von 5 Sternen Bewertung
5 von 5 Sternen BewertungVon Felix H.1. Juni 2018 • Geprüfter Kauf
Bewertungsprogramm bei Zazzle
...bei Zazzle geht offenbar (fast) alles, bin ziemlich begeistert :). Perfekt. Musste schwarze (!) Tintenflecken mit einem rauen Schwamm entfernen, die Aufnahme entstand danach. Man sieht ...nichts!
Originalprodukt
5.0 von 5 Sternen Bewertung
5 von 5 Sternen BewertungVon Conny W.13. Juni 2017 • Geprüfter Kauf
Mousepad
Bewertungsprogramm bei Zazzle
das Mousepad ist vom Gefühl her sehr dick aber weites kein Problem, ist mir nur aufgefallen
gut verpackt. Design ganz gut, Farben auch gut, wie erwartet
hoffe meiner Freundin gefällt es auch
Tags
Andere Informationen
Produkt ID: 144836916640059581
Gemacht am: 29.10.2012, 15:43
Bewertung: G